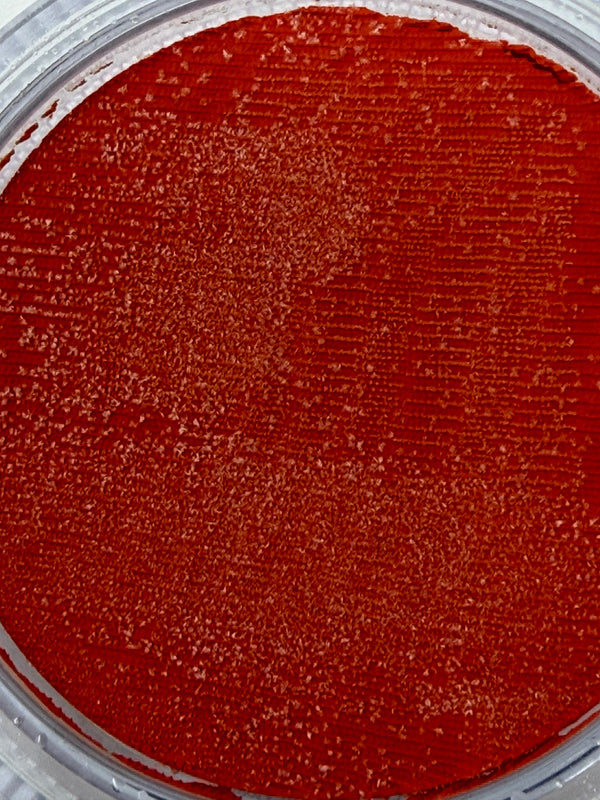

Great for water and beach face painting designs.
Diamond FX is one of the most popular face painting brands around. They are known for their great ability to layer and blend, allowing complex and beautiful looking designs.
Specifications:
- Leaves a smooth even finish.
- Water-based - remove with soap and water
How to Use:
Using a damp brush, sponge, or dauber, move your brush back and forth over the one stroke cake, parallel with the stripes to activate and load the paint. (Your flat brush should be 1 inch wide to load all the colors, or ¾, ½ or ¼ inch wide to pick up just a few of the colors). When your brush is fully loaded, paint the brush along the skin and watch the magic happen! All the colors will flow off the brush at the same time. You can create hundreds of designs by moving the brush in specific ways on the skin (see our tutorials for ideas).
Recommended for the Diamond FX Face Paint - Essential Orange - 30 grams - Clearance
Product title
Vendor
$19.99 | $24.99
Product title
Vendor
$19.99 | $24.99
Product title
Vendor
$19.99 | $24.99
Product title
Vendor